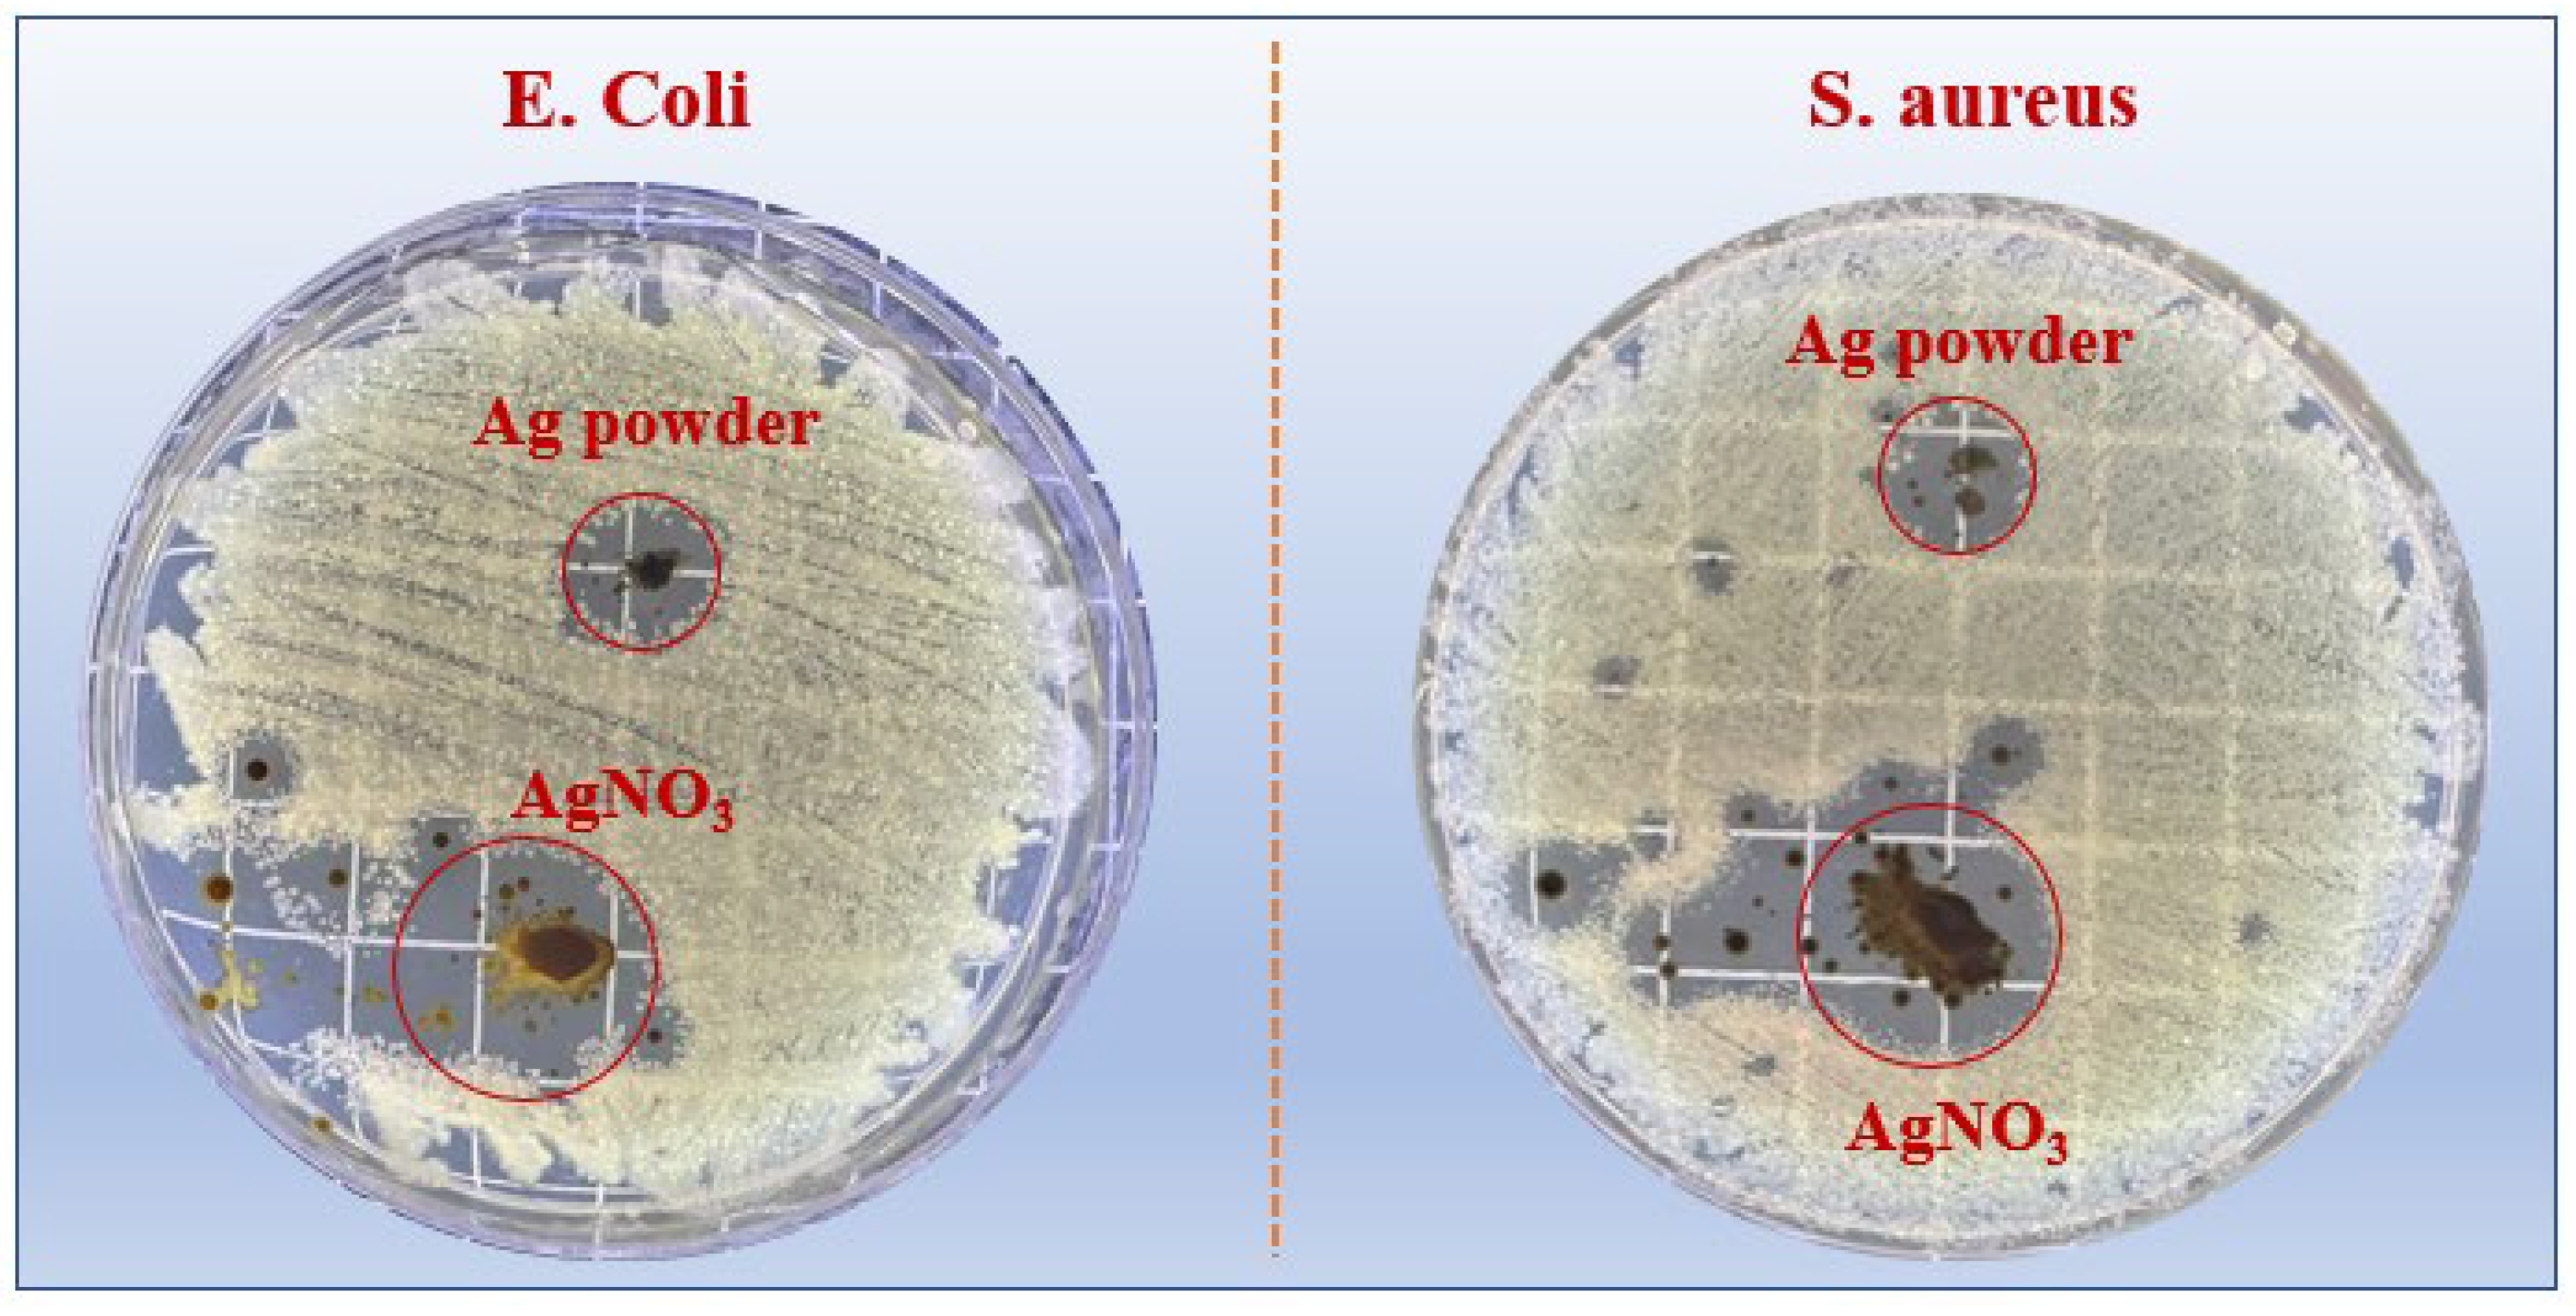
Coatings 14 00180 g010

Fabrication of Air Conditioning Antimicrobial Filter for Electrically Powered Port Tractors via Electrospinning Coating
Abstract
1. Introduction
2. Materials and Methods
2.1. Experimental Materials
2.2. Preparation of Antibacterial Membranes
2.3. Characterization Method
2.4. Antibacterial Activity Experiment
3. Results and Discussion
3.1. Morphology and Structure
3.2. X-ray Diffraction (XRD) and Fourier Transform Infrared Spectroscopy (FT-IR)
3.3. Antibacterial Activity
3.4. Antibacterial Mechanism
4. Conclusions
- The average diameter of PVA composite fibers prepared by electrospinning was at the nanometer level, distributed between 470 and 700 nm, which is much smaller than the diameter of the non-woven fibers (1.17 μm).
- The characterization results of XRD and FTIR indicate that pure PVA fibers and PVA/AgNP and PVA/AgNO3 composite fibers were successfully coated onto the surface of non-woven fiber membranes using electrospinning technology to prepare functional membranes with antibacterial properties.
- By comparing the antibacterial properties, it was found that PVA containing 1 wt% AgNO3 had the best antibacterial properties against E. coli and S. aureus, with clearance zones of inhibition of 26.00 mm and 17.30 mm, respectively.
- The antibacterial mechanism of silver particles against E. coli and S. aureus is mainly related to their adsorption on the cell membrane, disruption of the cell membrane’s integrity, permeation into the cell, and interaction with DNA and proteins.
Author Contributions
Funding
Institutional Review Board Statement
Informed Consent Statement
Data Availability Statement
Conflicts of Interest
References
- Li, C.; Dixit, P.; Welch, B.; Nigam, A.; Soriano, B.; Lee, J.; Russell, R.L.; Jiang, Y.; Zhu, H.; Karavalakis, G.; et al. Yard tractors: Their path to zero emissions. Transp. Res. Part D Transp. Environ. 2021, 98, 102972. [Google Scholar] [CrossRef]
- Fredianelli, L.; Bolognese, M.; Fidecaro, F.; Licitra, G. Classification of noise sources for port area noise mapping. Environments 2021, 8, 12. [Google Scholar] [CrossRef]
- Pahlavani, H.; Shayeh, J.S.; Nouralishahi, A.; Paroushi, M.S. Nano graphene porous/conductive polymer as a composite material for energy storage in supercapacitors. J. Appl. Polym. Sci. 2024, 141, e54812. [Google Scholar] [CrossRef]
- Dizaj, R.B.; Sabahi, N. Optimizing LSM-LSF composite cathodes for enhanced solid oxide fuel cell performance: Material engineering and electrochemical insights. World J. Adv. Res. Rev. 2023, 20, 1284–1291. [Google Scholar] [CrossRef]
- Dizaj, R.B.; Sabahi, N. Laboratory preparation of LSM and LSF sputtering targets using PTFE rings for deposition of SOFC thin film electrodes. World J. Adv. Eng. Technol. Sci. 2023, 10, 203–212. [Google Scholar] [CrossRef]
- Yang, X.; Lin, W.; Gong, R.; Zhu, M.; Springer, C. Transport decarbonization in big cities: An integrated environmental co-benefit analysis of vehicles purchases quota-limit and new energy vehicles promotion policy in Beijing. Sustain. Cities Soc. 2021, 71, 102976. [Google Scholar] [CrossRef]
- Qian, C. The development and property studies of nonwoven filtering materials for car air-conditioner. Adv. Mater. Res. 2011, 322, 373–376. [Google Scholar] [CrossRef]
- Ge, J.C.; Kim, J.Y.; Yoon, S.K.; Choi, N.J. Fabrication of low-cost and high-performance coal fly ash nanofibrous membranes via electrospinning for the control of harmful substances. Fuel 2019, 237, 236–244. [Google Scholar] [CrossRef]
- Ge, J.C.; Choi, N.J. Performance of electrospun nanofibrous membranes for trapping of BTX aromatic hydrocarbons and heavy metal ions: Mechanisms, isotherms and kinetics. J. Clean. Prod. 2019, 217, 388–397. [Google Scholar] [CrossRef]
- Bhardwaj, N.; Kundu, S.C. Electrospinning: A fascinating fiber fabrication technique. Biotechnol. Adv. 2010, 28, 325–347. [Google Scholar] [CrossRef]
- Agarwal, S.; Wendorff, J.H.; Greiner, A. Use of electrospinning technique for biomedical applications. Polymer 2008, 49, 5603–5621. [Google Scholar] [CrossRef]
- Ahmed, F.E.; Lalia, B.S.; Hashaikeh, R. A review on electrospinning for membrane fabrication: Challenges and applications. Desalination 2015, 356, 15–30. [Google Scholar] [CrossRef]
- Ge, J.C.; Wu, G.; Xu, G.; Song, J.H.; Choi, N.J. Synthesis of Polyvinyl Alcohol/Coal Fly Ash Hybrid Nano-Fiber Membranes for Adsorption of Heavy Metals in Diesel Fuel. Nanomaterials 2023, 13, 1674. [Google Scholar] [CrossRef]
- Lyu, C.; Zhao, P.; Xie, J.; Dong, S.; Liu, J.; Rao, C.; Fu, J. Electrospinning of nanofibrous membrane and its applications in air filtration: A review. Nanomaterials 2021, 11, 1501. [Google Scholar] [CrossRef]
- Li, J.; Zhang, D.; Yang, T.; Yang, S.; Yang, X.; Zhu, H. Nanofibrous membrane of graphene oxide-in-polyacrylonitrile composite with low filtration resistance for the effective capture of PM2.5. J. Membr. Sci. 2018, 551, 85–92. [Google Scholar] [CrossRef]
- Liu, C.; Hsu, P.-C.; Lee, H.-W.; Ye, M.; Zheng, G.; Liu, N.; Li, W.; Cui, Y. Transparent air filter for high-efficiency PM2.5 capture. Nat. Commun. 2015, 6, 6205. [Google Scholar] [CrossRef]
- Li, H.; Chen, X.; Lu, W.; Wang, J.; Xu, Y.; Guo, Y. Application of electrospinning in antibacterial field. Nanomaterials 2021, 11, 1822. [Google Scholar] [CrossRef] [PubMed]
- Zhao, Y.; Zhou, Y.; Wu, X.; Wang, L.; Xu, L.; Wei, S. A facile method for electrospinning of Ag nanoparticles/poly (vinyl alcohol)/carboxymethyl-chitosan nanofibers. Appl. Surf. Sci. 2012, 258, 8867–8873. [Google Scholar] [CrossRef]
- Ince Yardimci, A.; Durmus, A.; Kayhan, M.; Tarhan, O. Antibacterial Activity of AgNO3 Incorporated Polyacrylonitrile/Polyvinylidene Fluoride (PAN/PVDF) Electrospun Nanofibrous Membranes and Their Air Permeability Properties. J. Macromol. Sci. Part B 2022, 61, 749–762. [Google Scholar] [CrossRef]
- Yang, Y.; Zhang, Z.; Wan, M.; Wang, Z.; Zou, X.; Zhao, Y.; Sun, L. A facile method for the fabrication of silver nanoparticles surface decorated polyvinyl alcohol electrospun nanofibers and controllable antibacterial activities. Polymers 2020, 12, 2486. [Google Scholar] [CrossRef] [PubMed]
- Zhang, Z.; Wu, Y.; Wang, Z.; Zhang, X.; Zhao, Y.; Sun, L. Electrospinning of Ag Nanowires/polyvinyl alcohol hybrid nanofibers for their antibacterial properties. Mater. Sci. Eng. C 2017, 78, 706–714. [Google Scholar] [CrossRef]
- Ge, J.C.; Wu, G.; Yoon, S.K.; Kim, M.S.; Choi, N.J. Study on the preparation and lipophilic properties of polyvinyl alcohol (PVA) nanofiber membranes via green electrospinning. Nanomaterials 2021, 11, 2514. [Google Scholar] [CrossRef]
- Zhang, Z.; Wu, Y.; Wang, Z.; Zou, X.; Zhao, Y.; Sun, L. Fabrication of silver nanoparticles embedded into polyvinyl alcohol (Ag/PVA) composite nanofibrous films through electrospinning for antibacterial and surface-enhanced Raman scattering (SERS) activities. Mater. Sci. Eng. C 2016, 69, 462–469. [Google Scholar] [CrossRef] [PubMed]
- Jin, W.-J.; Jeon, H.J.; Kim, J.H.; Youk, J.H. A study on the preparation of poly(vinyl alcohol) nanofibers containing silver nanoparticles. Synth. Met. 2007, 157, 454–459. [Google Scholar] [CrossRef]
- Malakhov, S.N.; Dmitryakov, P.V.; Pichkur, E.B.; Chvalun, S.N. Nonwoven materials produced by melt electrospinning of polypropylene filled with calcium carbonate. Polymers 2020, 12, 2981. [Google Scholar] [CrossRef] [PubMed]
- Hang, A.T.; Tae, B.; Park, J.S. Non-woven mats of poly(vinyl alcohol)/chitosan blends containing silver nanoparticles: Fabrication and characterization. Carbohydr. Polym. 2010, 82, 472–479. [Google Scholar] [CrossRef]
- Amirjani, A.; Kamani, P.; Hosseini, H.R.M.; Sadrnezhaad, S.K. SPR-based assay kit for rapid determination of Pb2+. Anal. Chim. Acta 2022, 1220, 340030. [Google Scholar] [CrossRef] [PubMed]
- Amirjani, A.; Salehi, K.; Sadrnezhaad, S.K. Simple SPR-based colorimetric sensor to differentiate Mg2+ and Ca2+ in aqueous solutions. Spectrochim. Acta Part A Mol. Biomol. Spectrosc. 2022, 268, 120692. [Google Scholar] [CrossRef]
- Gorade, V.G.; Chaudhary, B.U.; Kale, R.D. Moisture management of polypropylene non-woven fabric using microcrystalline cellulose through surface modification. Appl. Surf. Sci. Adv. 2021, 6, 100151. [Google Scholar] [CrossRef]
- Bhajantri, R.F.; Ravindrachary, V.; Harisha, A.; Crasta, V.; Nayak, S.P.; Poojary, B. Microstructural studies on BaCl2 doped poly(vinyl alcohol). Polymer 2006, 47, 3591–3598. [Google Scholar] [CrossRef]
- Hebbar, V.; Bhajantri, R.; Naik, J.; Rathod, S.G. Thiazole yellow G dyed PVA films for optoelectronics: Microstructrural, thermal and photophysical studies. Mater. Res. Express 2016, 3, 075301. [Google Scholar] [CrossRef]
- Cheng, T.-H.; Lin, S.-B.; Chen, L.-C.; Chen, H.-H. Studies of the antimicrobial ability and silver ions migration from silver nitrate-incorporated electrospun nylon nanofibers. Food Packag. Shelf Life 2018, 16, 129–137. [Google Scholar] [CrossRef]
- Jiraroj, D.; Tungasmita, S.; Tungasmita, D.N. Silver ions and silver nanoparticles in zeolite A composites for antibacterial activity. Powder Technol. 2014, 264, 418–422. [Google Scholar] [CrossRef]
- Yusuf, Y.; Ghazali, M.J.; Otsuka, Y.; Ohnuma, K.; Morakul, S.; Nakamura, S.; Abdollah, M.F. Antibacterial properties of laser surface-textured TiO2/ZnO ceramic coatings. Ceram. Int. 2020, 46, 3949–3959. [Google Scholar] [CrossRef]
- Fayisa, W.O.; Tuli, N.F. Review on Staphylococcus aureus. Int. J. Nurs. Care Res. 2023, 1, 1–8. [Google Scholar]
- Shen, S.; Zhang, T.; Yuan, Y.; Lin, S.; Xu, J.; Ye, H. Effects of cinnamaldehyde on Escherichia coli and Staphylococcus aureus membrane. Food Control 2015, 47, 196–202. [Google Scholar] [CrossRef]
- Liao, C.; Li, Y.; Tjong, S.C. Bactericidal and cytotoxic properties of silver nanoparticles. Int. J. Mol. Sci. 2019, 20, 449. [Google Scholar] [CrossRef]
- Fröhlich, E.E.; Fröhlich, E. Cytotoxicity of nanoparticles contained in food on intestinal cells and the gut microbiota. Int. J. Mol. Sci. 2016, 17, 509. [Google Scholar] [CrossRef]
- Abdal Dayem, A.; Hossain, M.K.; Lee, S.B.; Kim, K.; Saha, S.K.; Yang, G.-M.; Choi, H.Y.; Cho, S.-G. The role of reactive oxygen species (ROS) in the biological activities of metallic nanoparticles. Int. J. Mol. Sci. 2017, 18, 120. [Google Scholar] [CrossRef]
- Ramalingam, B.; Parandhaman, T.; Das, S.K. Antibacterial effects of biosynthesized silver nanoparticles on surface ultrastructure and nanomechanical properties of gram-negative bacteria viz. Escherichia coli and Pseudomonas aeruginosa. ACS Appl. Mater. Interfaces 2016, 8, 4963–4976. [Google Scholar]

Disclaimer/Publisher’s Note: The statements, opinions and data contained in all publications are solely those of the individual author(s) and contributor(s) and not of MDPI and/or the editor(s). MDPI and/or the editor(s) disclaim responsibility for any injury to people or property resulting from any ideas, methods, instructions or products referred to in the content. |
© 2024 by the authors. Licensee MDPI, Basel, Switzerland. This article is an open access article distributed under the terms and conditions of the Creative Commons Attribution (CC BY) license (https://creativecommons.org/licenses/by/4.0/).
Share and Cite
Yoon, S.-K.; Pahn, L.-O.; Kyun, J.-J.; Cho, S.-H. Fabrication of Air Conditioning Antimicrobial Filter for Electrically Powered Port Tractors via Electrospinning Coating. Coatings 2024, 14, 180. https://doi.org/10.3390/coatings14020180
Yoon S-K, Pahn L-O, Kyun J-J, Cho S-H. Fabrication of Air Conditioning Antimicrobial Filter for Electrically Powered Port Tractors via Electrospinning Coating. Coatings. 2024; 14(2):180. https://doi.org/10.3390/coatings14020180
Chicago/Turabian StyleYoon, Sam-Ki, Lyong-Oon Pahn, Jeong-Jong Kyun, and Soon-Hwan Cho. 2024. "Fabrication of Air Conditioning Antimicrobial Filter for Electrically Powered Port Tractors via Electrospinning Coating" Coatings 14, no. 2: 180. https://doi.org/10.3390/coatings14020180
APA StyleYoon, S.-K., Pahn, L.-O., Kyun, J.-J., & Cho, S.-H. (2024). Fabrication of Air Conditioning Antimicrobial Filter for Electrically Powered Port Tractors via Electrospinning Coating. Coatings, 14(2), 180. https://doi.org/10.3390/coatings14020180





